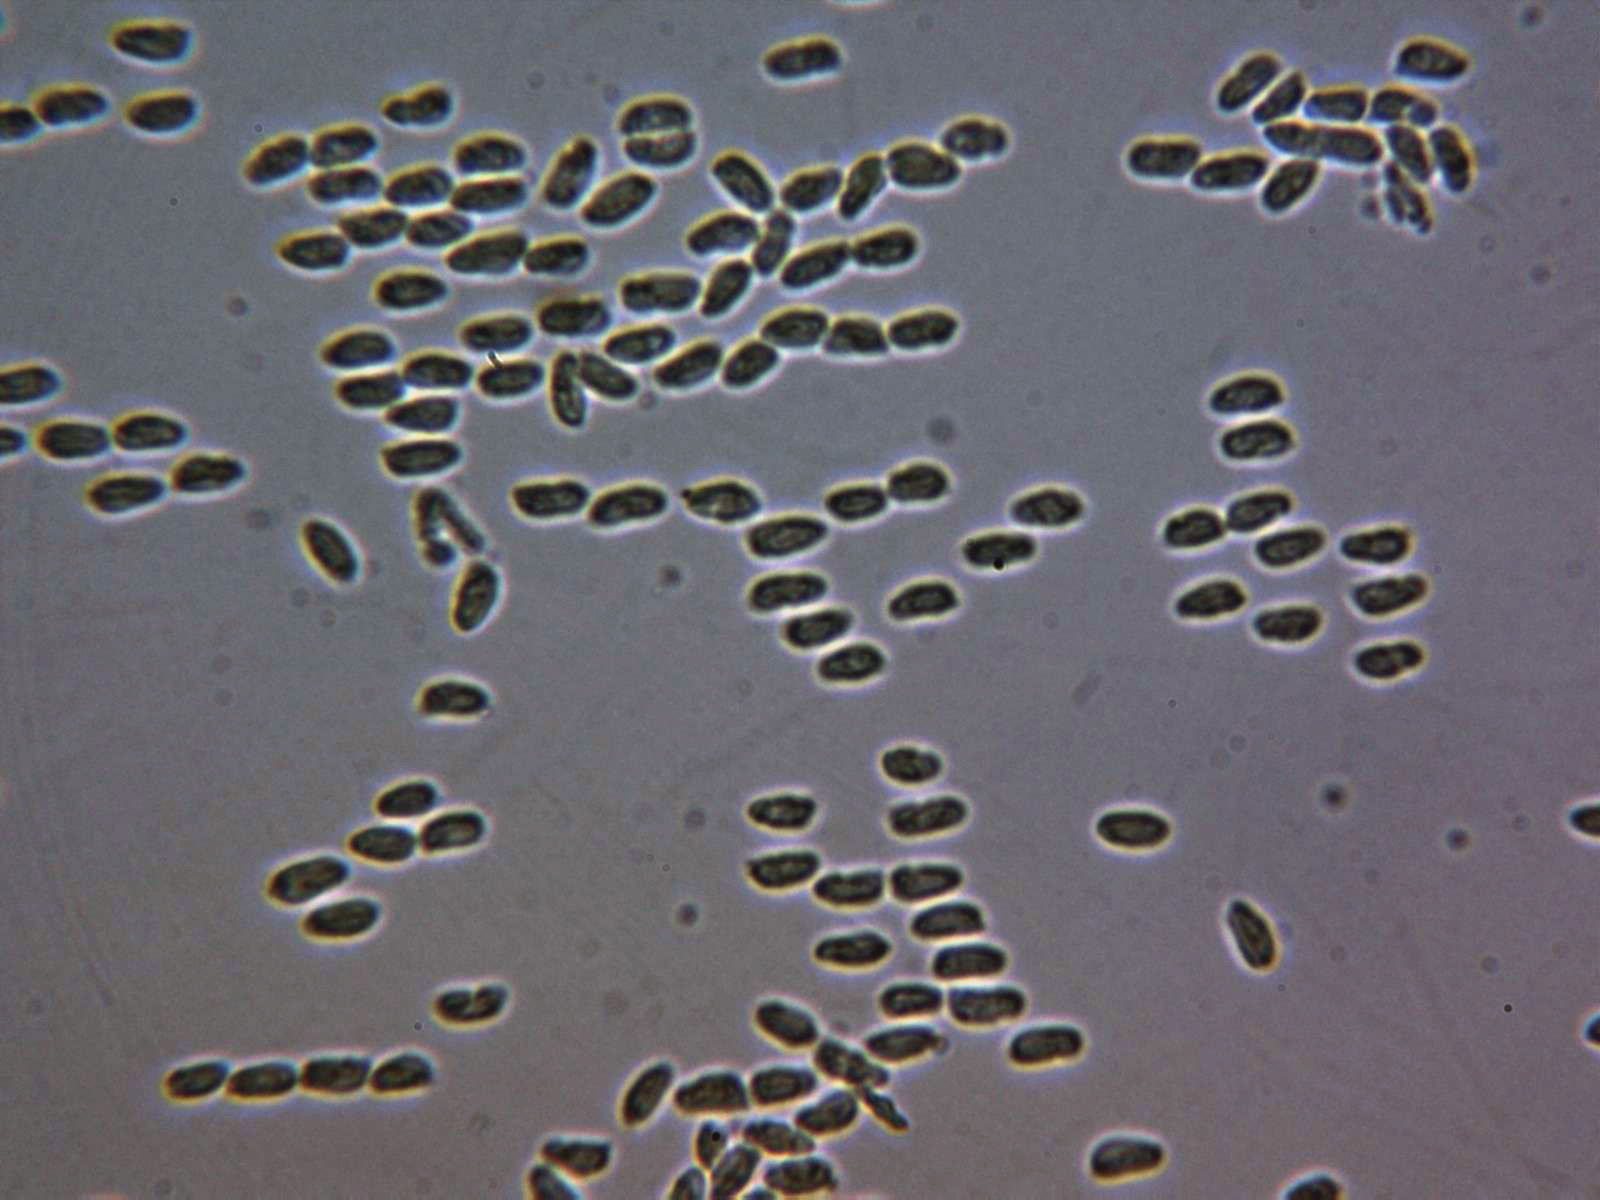

- Foro
- Foros sobre Micología de fungipedia
- Microscopía
- Rickenella mellea (Singer & Clémençon) Lamoure (1979)
 Rickenella mellea (Singer & Clémençon) Lamoure (1979)
Rickenella mellea (Singer & Clémençon) Lamoure (1979)
- Josep Torres
-
 Autor del tema
Autor del tema
- Fuera de línea
- Moderador
-

Menos
Más
- Mensajes: 8745
- Gracias recibidas: 8379
7 años 6 meses antes #99993
por Josep Torres
Hola a tod@s.
Especie fotografiada el pasado domingo, brotando sobre el musgo.
De muy pequeño tamaño, ninguna llegaba a 1 cm. el sombrero, brotando de manera dispersa sobre el musgo de una zona húmeda. Sombrero de color pardo amarillento, umbilicado y con transparencia radial.
Láminas decurrentes, espaciadas y con lamélulas de color más claro que el sombrero. Pié muy largo del mismo color que las láminas y ensanchado en la zona de unión con el sombrero.
La microscopía:
La pileipellis
Pileipellis a 400 aumentos, formada por hifas cilíndricas e hialinas con unas pequeñas y abundantes cristalizaciones por encima y en medio de estas.
Hifas de la suprapellis a 1000 aumentos.
El estípite
Parte superior del pié con abundantes caulocistidios, los de la imágen a 400 aumentos.
Caulocistidios a 1000 aumentos, ventrudos con un cuello largo y ligeramente capitados.
Hifas de la parte media del pié a 400 aumentos, aquí ya sin caulocistidios.
Los queilocistidios
Queilocistidios dispersos con la misma morfología de los caulocistidios
El himenio
Sección del himenio a 1000 aumentos.
Basidios de pequeño tamaño, mayoritariamente tetraspóricos, aunque también pude observar alguno de bispórico.
Las esporas
Esporas de esporada natural en agua destilada.
Esporas en Rojo Congo diluido, congófilas.
Esporas en Reactivo de Melzer.
Las medidas en agua destilada de 5;5,9 (6,4) X 2,4;3,2 micras.
Y en Rojo Congo de 5,3;6,9 X 2,9;3,2 micras.
Esta es una que no me había encontrado hasta el momento, es decir un "cromo nuevo"
Saludos a tod@s.
Especie fotografiada el pasado domingo, brotando sobre el musgo.
De muy pequeño tamaño, ninguna llegaba a 1 cm. el sombrero, brotando de manera dispersa sobre el musgo de una zona húmeda. Sombrero de color pardo amarillento, umbilicado y con transparencia radial.
Láminas decurrentes, espaciadas y con lamélulas de color más claro que el sombrero. Pié muy largo del mismo color que las láminas y ensanchado en la zona de unión con el sombrero.
La microscopía:
La pileipellis
Pileipellis a 400 aumentos, formada por hifas cilíndricas e hialinas con unas pequeñas y abundantes cristalizaciones por encima y en medio de estas.
Hifas de la suprapellis a 1000 aumentos.
El estípite
Parte superior del pié con abundantes caulocistidios, los de la imágen a 400 aumentos.
Caulocistidios a 1000 aumentos, ventrudos con un cuello largo y ligeramente capitados.
Hifas de la parte media del pié a 400 aumentos, aquí ya sin caulocistidios.
Los queilocistidios
Queilocistidios dispersos con la misma morfología de los caulocistidios
El himenio
Sección del himenio a 1000 aumentos.
Basidios de pequeño tamaño, mayoritariamente tetraspóricos, aunque también pude observar alguno de bispórico.
Las esporas
Esporas de esporada natural en agua destilada.
Esporas en Rojo Congo diluido, congófilas.
Esporas en Reactivo de Melzer.
Las medidas en agua destilada de 5;5,9 (6,4) X 2,4;3,2 micras.
Y en Rojo Congo de 5,3;6,9 X 2,9;3,2 micras.
Esta es una que no me había encontrado hasta el momento, es decir un "cromo nuevo"
Saludos a tod@s.
Por favor, Identificarse para unirse a la conversación.
- Juan Andrés Román
-

- Fuera de línea
- Spammer
-

Menos
Más
- Mensajes: 2558
- Gracias recibidas: 2756
7 años 6 meses antes #99995
por Juan Andrés Román
Respuesta de Juan Andrés Román sobre el tema Rickenella mellea (Singer & Clémençon) Lamoure (1979)
Estupendo post Josep, con esta me has vuelto a pillar, no la tengo, no como sus hermanas Rickenella fibula y Rickenella swartzii que he tenido el placer de encontrarlas en múltiples ocasiones.
Un abrazo.
Un abrazo.
El siguiente usuario dijo gracias: Josep Torres
Por favor, Identificarse para unirse a la conversación.
- javier
-

- Fuera de línea
- Moderador
-

Menos
Más
- Mensajes: 5617
- Gracias recibidas: 4356
7 años 6 meses antes - 7 años 6 meses antes #99997
por javier
Respuesta de javier sobre el tema Rickenella mellea (Singer & Clémençon) Lamoure (1979)
Interesante tema, lo digo por que creo que esta es mas habitual de lo que pensamos, lo que ocurre es que cuando la vemos y la volvemos a ver y de nuevo la vemos acabamos ignorándola, pero después de este post iremos atentos por si la requetevemeos 
Ahora lo que hacen falta son precipitaciones, pues ayer y hoy nuevamente estamos en alerta amarilla por altas temperaturas ofuuu :que caló whistle:
ofuuu :que caló whistle:
Ahora lo que hacen falta son precipitaciones, pues ayer y hoy nuevamente estamos en alerta amarilla por altas temperaturas
Última Edición: 7 años 6 meses antes por javier.
El siguiente usuario dijo gracias: Josep Torres
Por favor, Identificarse para unirse a la conversación.
- Jon Joseba Arnedo
-

- Fuera de línea
- Moderador
-

Menos
Más
- Mensajes: 3702
- Gracias recibidas: 3555
7 años 6 meses antes #100007
por Jon Joseba Arnedo
Respuesta de Jon Joseba Arnedo sobre el tema Rickenella mellea (Singer & Clémençon) Lamoure (1979)
Buen cromo, si señor! esa Rickenella es la que me falta de la "cole" pero me parece que la tengo localizada, esa cae este año, Juan!
Un abrazo
Un abrazo
El siguiente usuario dijo gracias: Josep Torres
Por favor, Identificarse para unirse a la conversación.
- Josep Torres
-
 Autor del tema
Autor del tema
- Fuera de línea
- Moderador
-

Menos
Más
- Mensajes: 8745
- Gracias recibidas: 8379
7 años 6 meses antes #100012
por Josep Torres
Respuesta de Josep Torres sobre el tema Rickenella mellea (Singer & Clémençon) Lamoure (1979)
Muchas gracias a los tres, en estos momentos la que me falta a mí es la Rickenella swartzii, así que toca estar atento, la Rickenella fibula es muy común por mi zona y ya me la he encontrado en muchas ocasiones.
Suerte con la Rickenella mellea
Un fuerte abrazo a los tres
Suerte con la Rickenella mellea
Un fuerte abrazo a los tres
Por favor, Identificarse para unirse a la conversación.
- Koldobika
-

- Fuera de línea
- Navegador Dorado
-

Menos
Más
- Mensajes: 178
- Gracias recibidas: 237
7 años 6 meses antes #100016
por Koldobika
Respuesta de Koldobika sobre el tema Rickenella mellea (Singer & Clémençon) Lamoure (1979)
Interesante especie Josep, enhorabuena por el avistamiento.Un abrazo
El siguiente usuario dijo gracias: Josep Torres
Por favor, Identificarse para unirse a la conversación.
- Foro
- Foros sobre Micología de fungipedia
- Microscopía
- Rickenella mellea (Singer & Clémençon) Lamoure (1979)
Tiempo de carga de la página: 0.221 segundos

Foro de micología